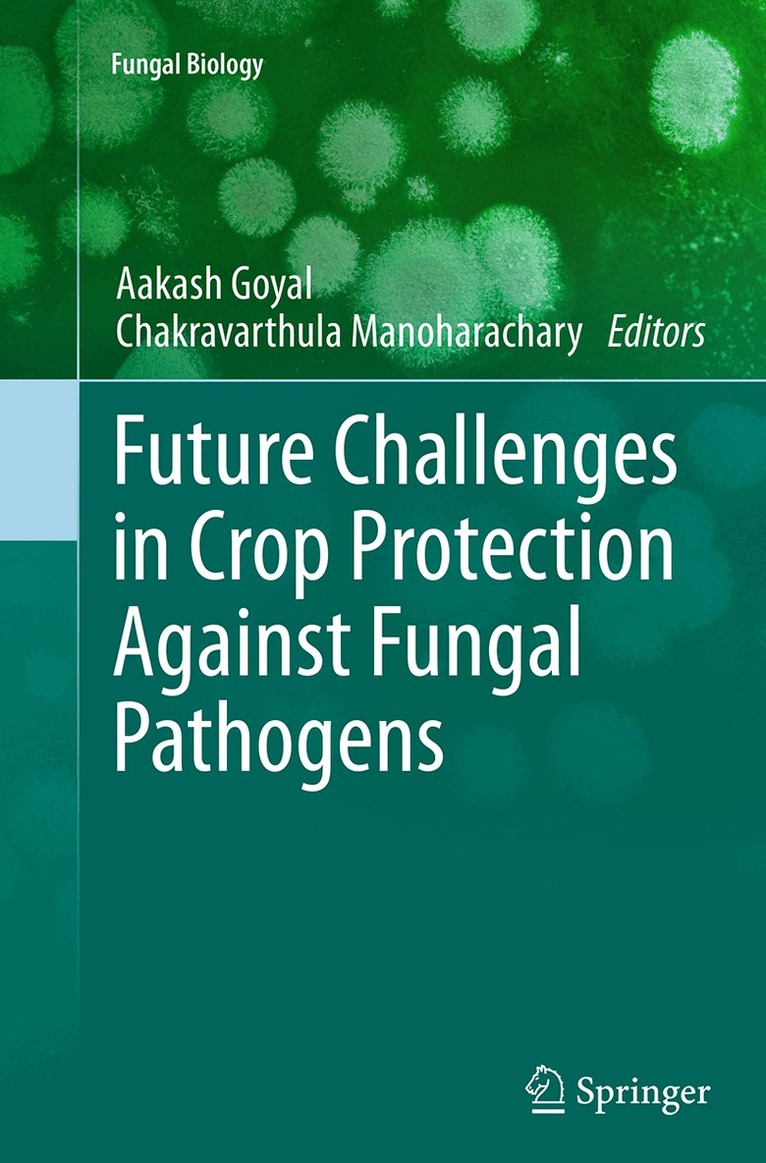

Aakash Goyal – författare
Visar alla böcker från författaren Aakash Goyal. Handla med fri frakt och snabb leverans.
6 produkter
6 produkter
Inbunden, Engelska, 2014
1 925 kr
Skickas inom 10-15 vardagar
This volume presents the issues and challenges of crop pathogens and plant protection. Composed of the latest knowledge in plant pathology, the book covers topics such as fungal diseases of the groundnut, plant growth promoting rhizobacteria, plant pathogenic fungi in the genomics era, the increased virulence of wheat rusts and oat fungal diseases.Written by experienced and internationally recognized scientists in the field, Future Challenges in Crop Protection Against Fungal Pathogens is a concise yet comprehensive resource valuable for both novice as well as experienced plant scientists and researchers.
Häftad, Engelska, 2016
1 925 kr
Skickas inom 10-15 vardagar
This volume presents the issues and challenges of crop pathogens and plant protection. Composed of the latest knowledge in plant pathology, the book covers topics such as fungal diseases of the groundnut, plant growth promoting rhizobacteria, plant pathogenic fungi in the genomics era, the increased virulence of wheat rusts and oat fungal diseases.Written by experienced and internationally recognized scientists in the field, Future Challenges in Crop Protection Against Fungal Pathogens is a concise yet comprehensive resource valuable for both novice as well as experienced plant scientists and researchers.
Häftad, Engelska
1 349 kr
Skickas inom 3-6 vardagar
Del 16 - Sustainable Agriculture Reviews
Sustainable Agriculture Reviews
Cereals
Inbunden, Engelska, 2015
1 073 kr
Skickas inom 10-15 vardagar
Sustainable agriculture is a rapidly growing field aiming at producing food and energy in a sustainable way for humans and their children.
Inbunden, Engelska, 2012
1 604 kr
Skickas inom 5-8 vardagar
Inbunden, Engelska, 2013
1 667 kr
Skickas inom 5-8 vardagar